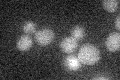
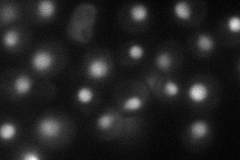
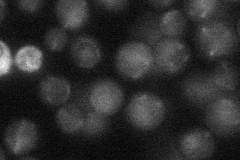
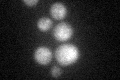

View description
JmjC domain family histone demethylase specific for H3-K36, similar to proteins found in human, mouse, drosophila, X. laevis, C. elegans, and S. pombe
Localization:
Intensity:
Fold change:
Significance:
-
C’ GFP library in SD
below threshold16.71 -
N' NOP1pr-GFP in SD
nucleus53.1369 -
N' TEF2pr-mCherry in SD

nucleus31.2014 -
N' NATIVEpr-GFP in SD
ambiguous20.7136 -
N' TEF2pr-VC and Cyto-VN in SD

nucleus31.1332 -
C’ GFP library in SD+DTT
cytosol19.271.15No -
C’ GFP library in SD+H2O2

cytosol19.11.14No -
C’ GFP library in Starvation Media

cytosol15.790.94No -
C’ GFP library on the background of Pup2-DaMP

below threshold -
C’ GFP library on the background of CCT mutant

below threshold17.31931.03605No
